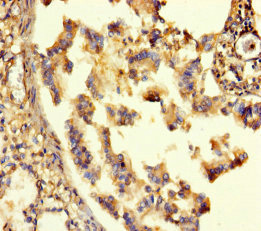

GABRA6 Antibody
-
中文名稱:GABRA6兔多克隆抗體
-
貨號:CSB-PA623078LA01HU
-
規格:¥440
-
圖片:
-
其他:
產品詳情
-
產品名稱:Rabbit anti-Homo sapiens (Human) GABRA6 Polyclonal antibody
-
Uniprot No.:
-
基因名:
-
別名:GABA A antibody; GABA A Receptor alpha 6 polypeptide antibody; GABA A receptor alpha 6 antibody; GABA A receptor subunit alpha 6 antibody; GABA subunit A receptor alpha 6 antibody; GABA(A) receptor subunit alpha-6 antibody; GABRA 6 antibody; GABRA6 antibody; Gamma aminobutyric acid A receptor alpha 6 antibody; Gamma aminobutyric acid GABA A receptor alpha 6 antibody; Gamma aminobutyric acid receptor subunit alpha 6 antibody; Gamma-aminobutyric acid receptor subunit alpha-6 antibody; GBRA6_HUMAN antibody; MGC116903 antibody; MGC116904 antibody
-
宿主:Rabbit
-
反應種屬:Human
-
免疫原:Recombinant Human Gamma-aminobutyric acid receptor subunit alpha-6 protein (20-242AA)
-
免疫原種屬:Homo sapiens (Human)
-
標記方式:Non-conjugated
本頁面中的產品,GABRA6 Antibody (CSB-PA623078LA01HU),的標記方式是Non-conjugated。對于GABRA6 Antibody,我們還提供其他標記。見下表:
-
克隆類型:Polyclonal
-
抗體亞型:IgG
-
純化方式:>95%, Protein G purified
-
濃度:It differs from different batches. Please contact us to confirm it.
-
保存緩沖液:Preservative: 0.03% Proclin 300
Constituents: 50% Glycerol, 0.01M PBS, PH 7.4 -
產品提供形式:Liquid
-
應用范圍:ELISA, IHC
-
推薦稀釋比:
Application Recommended Dilution IHC 1:20-1:200 -
Protocols:
-
儲存條件:Upon receipt, store at -20°C or -80°C. Avoid repeated freeze.
-
貨期:Basically, we can dispatch the products out in 1-3 working days after receiving your orders. Delivery time maybe differs from different purchasing way or location, please kindly consult your local distributors for specific delivery time.
-
用途:For Research Use Only. Not for use in diagnostic or therapeutic procedures.
相關產品
靶點詳情
-
功能:GABA, the major inhibitory neurotransmitter in the vertebrate brain, mediates neuronal inhibition by binding to the GABA/benzodiazepine receptor and opening an integral chloride channel.
-
基因功能參考文獻:
- TMEM132D, COMT and GABRA6 gene polymorphisms may influence susceptibility to panic disorder(PD) and major depressive disorder(MDD)in Japanese adults; these variants may increase vulnerability to PD by modulating oligodendrocytes and GABA and dopaminergic functions in related brain regions, altering neuronal processing of anxiety-related emotional signals PMID: 25974322
- NOS3, GABRA6, child abuse, neighborhood crime Gene x Gene, Environment x Environment, and Gene x Environment interactions are associated with different patterns of respiratory sinus arrhythmia reactivity. PMID: 26535938
- The gene-gene interaction at two loci involving GABRA6 and Synapsin II revealed a significant association for development of idiopathic generalized epilepsy. PMID: 25088614
- genetic association study in Chinese Han population: Data suggest an SNP in GABRA6 (rs3219151) is associated with decreased predisposition to schizophrenia via alteration of miroRNA binding to target in 3-prime-untranslated region of GABRA6 mRNA. PMID: 23332465
- GABRA6 mutation, R46W, was identified as a susceptibility gene that may contribute to the pathogenesis of childhood absence epilepsy and cause neuronal disinhibition and increase in seizures via a reduction of alphabetagamma and alphabetadelta receptor function and expression PMID: 21930603
- Part of the interindividual differences observed for anxiety traits measured by the Harm Avoidance dimension could be explained by the GABRA6 gene variability. PMID: 21902679
- significant involvement of alpha (GABRA6) and beta (GABRB2) subunits of GABA(A) receptor in epilepsy susceptibility in north Indian population PMID: 21420396
- studies have found prefrontal cortical GABA(A) receptor alpha subunit alterations in schizophrenia PMID: 20100621
- These findings support a role for the serotonin transporter and GABA(A) alpha6 subunit in depression-related traits. PMID: 14744464
- The T1521C polymorphism in the GABRA6 gene is associated with specific personality characteristics as well as a marked attenuation in hormonal and blood pressure responses to psychological stress. PMID: 15197399
- GABRA6 expression is regulated by NFI in cerebellar granule neurons PMID: 15466411
- Findings support a role for GABRA6 (Pro385Ser) in perceived parenting. PMID: 16402352
- Polymorphism not associated with panic disorder. PMID: 17167337
- Chinese patients with certain psychiatric characteristics and GABRA6 heterozygosity are probably predisposed to functional heartburn PMID: 17295876
- The T allele of the 1519T>C GABA(A)alpha6 gene may be one of the modulating factors associated with changes in craving for alcohol and food during treatment of patients with alcohol dependence. PMID: 18616664
- Significant matching effects were found for polymorphisms at the DRD2, GABRA6 and GABRB2 gene. In addition, a trend was found for the OPRM1 polymorphism. PMID: 19523047
顯示更多
收起更多
-
亞細胞定位:Cell junction, synapse, postsynaptic cell membrane; Multi-pass membrane protein. Cell membrane; Multi-pass membrane protein.
-
蛋白家族:Ligand-gated ion channel (TC 1.A.9) family, Gamma-aminobutyric acid receptor (TC 1.A.9.5) subfamily, GABRA6 sub-subfamily
-
數據庫鏈接:
Most popular with customers
-
-
YWHAB Recombinant Monoclonal Antibody
Applications: ELISA, WB, IHC, IF, FC
Species Reactivity: Human, Mouse, Rat
-
Phospho-YAP1 (S127) Recombinant Monoclonal Antibody
Applications: ELISA, WB, IHC
Species Reactivity: Human
-
-
-
-
-